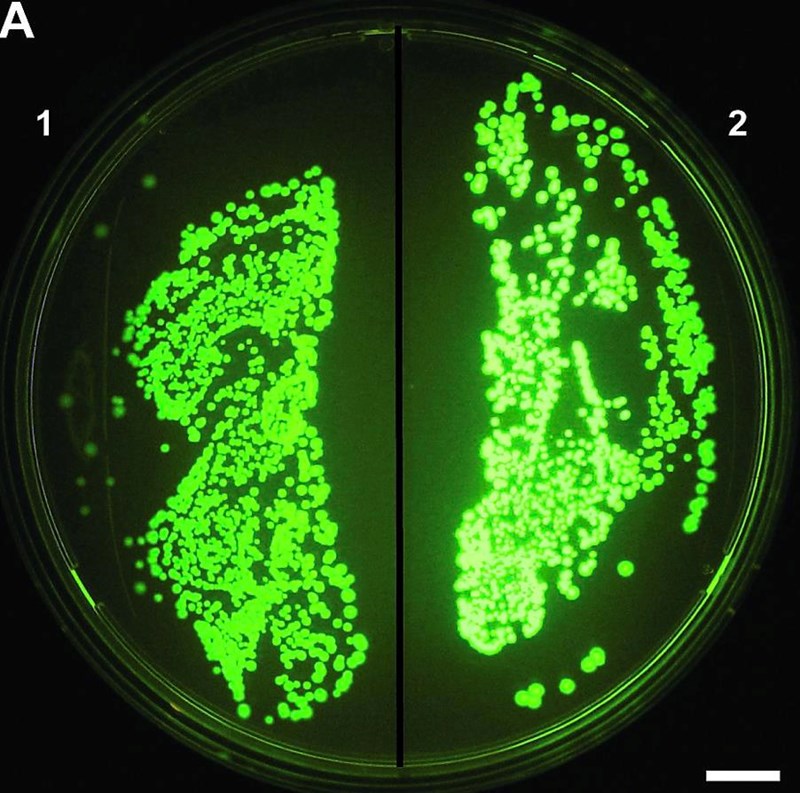

Resonerar över transformationslabb av DNA
Tjenare, jag förstår inte riktigt vad för funktion transformations solution och heat shocking har när det gäller transformationen av pGLO i E.coli.
Jag tänker personligen att Transformation Solution innehåller CaCl2 och att detta på någotsätt luckrar upp membranet och ökar permeabiliteten för DNA (men förstår har ingen förklaring till hur det sker). Skulle inte dock TS fylla samma funktion som heat shock då samma funktion som TS? Förresten använder jag rätt begrepp när jag säger "permeabiliteten" för DNA eller skall ett annat ord användas?
Transformation (=upptag av genetiskt material) görs av bakterier i deras naturliga miljö som ett utvecklat sätt att öka deras fitness. Bakterier har system för att underlätta utbyte av bitar av DNA eller hela plasmider mellan varandra. Denna förmåga utnyttjar vi för att föra in gener i form av plasmider in i bakterier i t.ex. forskingssyfte och bioteknologiapplikationer.
pGLO är en plasmid som kodar för grönt fluorescerande protein (GFP), vilket är en vanlig rapportör inom molekylärbiologin. Om plasmiden tas upp av bakterien, och bildar GFP kan det lätt detekteras, då proteinet fluorescerar grönt i bl.a. UV-ljus inuti bakterierna.
Du har inte skrivit vad ni gjorde, men jag misstänker att ni tillsatt "transformation solution", pGLO till E. coli och genomfört heat shock.
I DNA finns det ju en fosfodiesterbinding mellan varje bas, och varje fosfatgrupp har en negativ laddning vid normalt pH. Och i en större bit dubbelsträngat DNA, som en plasmid finns det massor av fosfodiesterbindingar, således har plasmiden massor av negativa laddningar. I bakteriens naturliga miljö attraherar dessa negativa laddningar positiva joner och laddningen balanseras. Kalciumjonerna attraheras till DNA och bildar ett komplex med DNA, som är ännu lättare för bakterierna att ta upp än om t.ex. natriumjoner skulle binda till DNA. Så för att underlätta upptaget plasmiden tillsätts kaliumjonerna.
Uppluckringen av bakterierna kommer istället ifrån heat shock, där den högre värmen chockar hela bakteriecellen, vilket dels skadar cellmembranet/väggen och även aktiverar en reparationsprocess för att hantera skador från värme chocken. Både skadan på den yttre barriären och reparationen underlättar upptaget av DNA, även din plasmid.